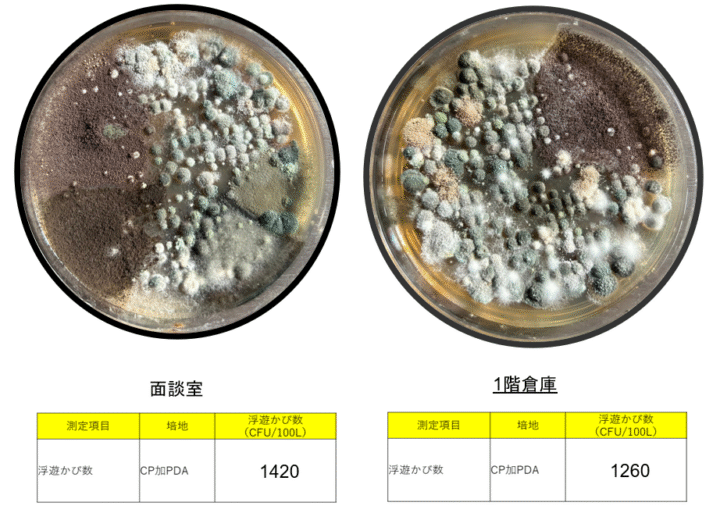

ある医療施設より、院内で発生しているカビについて調査のご依頼をいただき、ハーツリッチ株式会社(ハーツクリーン事業部)が現地調査を実施しました。
病院は高い衛生管理が求められる施設であり、カビの発生は環境面・健康面の双方に影響を及ぼす可能性があるため、迅速かつ正確な対応が重要となります。
今回は、付着菌検査・浮遊菌検査・含水率調査を実施し、院内で確認されたカビの状況や発生要因を確認しました。
以下では、その調査内容と結果を、実際の事例としてご紹介します。
1. 現地で確認されたカビの状況
今回の調査では、各種検査を行う前段階として、まず院内の状況を目視で確認しました。
その結果、壁紙、天井、物品、エアコン内部など、複数の箇所でカビの発生や結露、湿気の偏りが見られました。
以下では、現地で実際に確認された主な状況を、写真とあわせて整理します。
1-1. 壁紙や天井の広範囲に広がっているカビ


1階面談室および倉庫では、壁や天井の広範囲にカビの発生が見られました。
特に天井面は黒く変色している範囲が広く、天井全体に広がっているような状態でした。
1-2. 椅子など物品へのカビ付着


院内に設置されている家具や物品にも、カビの付着が確認されました。
これらは日常的に人が触れるため、衛生面の観点からも注意が必要な状態でした。
1-3. 天井裏で確認された異常な湿度と結露

天井裏の調査では、湿度および結露が異常に高い状態が確認されました。
特に、エリアによって結露量に大きな差があり、通常の結露とは考えにくい状況でした。
1-4. エアコン内部に発生していたカビと結露

エアコン内部では、広範囲にカビの発生が確認され、あわせて結露も見られました。
エアコンは空気を循環させる設備であるため、内部のカビは院内全体への拡散リスクにつながります。
2. 見た目では分からない汚染を数値化する「付着菌検査」
目視確認の結果、院内の複数箇所で明らかなカビの発生が確認されましたが、カビや細菌の汚染は、見た目だけでは正確に把握できないケースも少なくありません。
そこで今回は、壁の表面(100cm²)から菌を採取し、表面に付着している菌の量を数値として測定する付着菌検査を実施しました。
2-1. 検査の目的と判定基準
付着菌の量は「CFU(コロニー形成単位)」という数値で表され、数値が高いほど菌が多く付着していることを意味します。
以下の基準に沿って、汚染度を判定しています。
| 菌数(CFU/100cm²) | 判定 |
|---|---|
| 1〜500 | 清潔 |
| 501〜3,000 | 注意 |
| 3,001以上 | 汚染 |
測定には、微生物蛍光画像測定器を使用しました。
この測定方法は、培養法では検出が難しい低温菌・高温菌・嫌気性菌なども含めて測定できるため、表面に付着している菌の実態をより正確に把握することが可能です。
2-2. 検査結果
各調査箇所における付着菌検査の結果は、以下のとおりです。
| 採取場所 | 生菌数 | 死菌数 | 総菌数 | 判定 |
|---|---|---|---|---|
| 1階 面談室 壁面 | 17,630 | 6,530 | 24,160 | 汚染 |
| 1階 廊下 壁面 | 6,620 | 460 | 7,080 | 汚染 |
| 2階 廊下 壁面 | 6,550 | 2,120 | 8,670 | 汚染 |
| 3階 廊下 壁面 | 1,840 | 770 | 2,610 | 注意 |
特に1階面談室では24,160CFUと、基準値(500CFU以下)の約48倍という極めて高い数値が確認されました。
2-3. 見た目はきれいでも高菌数のケース

こちらの1階廊下の壁面は、外見上は清潔に見える状態でしたが、付着菌検査の結果、7,000〜8,000CFUという「汚染レベル」に該当する数値が確認されました。
表面に目立った汚れやカビが見られない場合でも、菌が残存している可能性が考えられます。
見た目だけで安全性を判断できないのがカビ問題の難しさであり、特に医療施設ではより慎重な評価と対応が求められます。
3. 空気中のカビを「見える化」する浮遊菌検査
カビが発生している建物では、壁や床だけでなく空気中にも菌が漂っていることがあるため、今回は建物全体の空気環境を把握する目的で浮遊菌検査を行いました。
3-1. 検査の目的と判定基準
浮遊菌検査とは建物内の空気にどの程度カビが含まれているかを調べる検査です。
カビの量は「CFU/100L(100リットルあたりのコロニー形成単位)」という数値で表されます。
以下の基準に沿って、空気の汚染度を判定しています。
| 区分 | 判定基準(CFU/100L) |
|---|---|
| 清潔区域 | 5 以下 |
| 準清潔区域 | 20 以下 |
| 準汚染区域 | 21〜99 |
| 汚染区域 | 100 以上 |
3-2. 検査結果:多くのポイントが「汚染区域」
今回の測定では、院内の複数箇所で100CFU/100Lを大きく上回る数値が確認されました。
| 測定場所 | 浮遊カビ数 | 判定 |
|---|---|---|
| 1階 廊下 | 110 | 汚染区域 |
| 1階 倉庫 | 1,260 | 汚染区域(極めて高い) |
| 1階 面談室 | 1,420 | 汚染区域(極めて高い) |
| 2階 階段 | 130 | 汚染区域 |
| 2階 ナースステーション | 290 | 汚染区域 |
| 3階 リネン周辺 | 250 | 汚染区域 |
| 保護室2号 | 140 | 汚染区域 |
1階面談室(1,420CFU/100L)と1階倉庫(1,260CFU/100L)は、清潔区域の基準(5CFU以下)と比較して250倍以上という深刻な状況でした。
3-3. 検出された主な菌の種類
今回の検査では、建物内の空気および壁面から、主に以下のカビが確認されました。
- クラドスポリウム(黒カビ)
湿度や結露の影響を受けやすく、壁紙の裏側や窓まわり、天井付近などで発生しやすいカビです。 - アスペルギルス
広く分布するカビで、胞子が空気中に拡散しやすい特徴があります。
中でも問題となったのがアスペルギルス・ニガー(Aspergillus niger)です。
湿度の高い環境で急速に増殖しやすく、免疫力が低下している方や呼吸器系に影響を及ぼすリスクがあるため、医療施設では特に注意が必要です。
実際に、1階面談室および倉庫では、このアスペルギルス・ニガーが大量に確認されました。
4. 壁の含水率で分かった「結露のサイン」
カビの発生を防ぐうえで重要なのが、壁や天井内部に含まれる水分量(含水率)です。
見た目が乾いているように見えても、内部に水分が残っている状態では、カビが再発しやすくなります。
4-1. 含水率の判定基準
石膏ボードの含水率は、以下を目安に判定しています。
| 含水率 | 状態 |
|---|---|
| 0〜1.0% | 乾いている |
| 1.0〜2.0% | 湿気っている |
| 2.0%以上 | 濡れている |
4-2. 高含水が見られたポイント
測定の結果、複数箇所で 2.0%以上の高い含水率(濡れている状態) が確認されました。

| 測定場所 | 含水率 | 状態 |
|---|---|---|
| 1階 面談室 | 2.2〜5.0% | 濡れている(異常に高い) |
| 1階 倉庫 | 2.3〜4.0% | 濡れている(異常に高い) |
| 1階 病室 | 1.6〜2.3% | 濡れている |
| 1階 廊下 | 2.3〜2.7% | 濡れている |
特に、1階面談室(最大5.0%)と倉庫(最大4.0%)では、菌数が多く確認された箇所と含水率の高い箇所が一致しており、結露などによる水分滞留がカビ増殖の要因となっていた可能性が示唆されました。
5. カビ発生の主な原因についての考察
今回の調査結果を総合的に整理したところ、カビの発生について次の点が要因として考えられます。
5-1. 汚染の中心は1階面談室

各種検査の結果から、1階面談室がカビ汚染の中心となっている可能性が高いことが分かりました。
同エリアでは、壁表面の付着菌数が基準値の約48倍、空気中の浮遊カビ数が約280倍と高い数値を示しています。
さらに含水率も通常の5倍以上と、内部に水分が多く滞留している状態が確認されました。
5-2. 建物側の不具合の可能性
異常な結露や高い含水率が確認されたのは、主に1階面談室および倉庫周辺に集中していました。
一方で、他のエリアでは同様の症状が見られないことから、日常的な使い方だけが原因とは考えにくく、建物構造や設備などに起因する何らかの不具合が発生している可能性が示唆されます。
そのため、今後は詳細な検査を行い、原因を特定したうえで改善を行うことが必要と考えられます。
6. 調査結果を踏まえた対応内容

今回の調査結果から、本件のカビ問題は表面清掃のみで解決できる状態ではないと判断されました。
空気中・表面のいずれにおいても高い汚染が確認されており、健康面への影響や、拡散力の高いカビによる問題の長期化が懸念されます。
そのため、本件では部分的な対処ではなく、空間全体を対象とした是正を前提に対応を行うことが重要と考えられます。
対応の考え方は以下のとおりです。
- 結露や高含水が確認された箇所について、原因を特定し、建物側の不具合を改善する
- 壁紙の裏側や天井裏など、内部まで侵食しているカビについては、必要に応じて撤去を含む除カビ作業を行う
- 除カビ後は、防カビ処理を実施し、再びカビが発生しにくい環境を整える
これらの対応を進めることで、カビの根本原因に対処し、空間全体の状態を適切に管理していくことが可能になります。
7. まとめ:科学的な調査が「安心できる環境」をつくる
病院のように、免疫力が低下している方や体調に配慮が必要な方が利用する施設では、カビの問題は健康面に直結する重要な課題です。
見た目では判断しにくいカビ汚染も、空気中のカビ量や壁内部の含水率を数値で把握することで、発生原因や改善点を明確にすることができます。
今回の調査では、1階面談室を中心に各数値が基準値を大きく上回り、表面清掃だけでは不十分な状態であることが確認されました。
原因の是正から除カビ・防カビまでを含めた対応が必要な状況といえます。
「見た目はきれいなのにカビ臭がする」「清掃しても改善しない」と感じている場合は、科学的な調査によって現状を把握することが、解決への第一歩となります。
ハーツリッチ株式会社では、建物の状態や利用環境に応じた調査・分析を行い、状況に合わせた改善の方向性をご提案しています。
同様の不安や課題を感じている場合は、お気軽にご相談ください。

